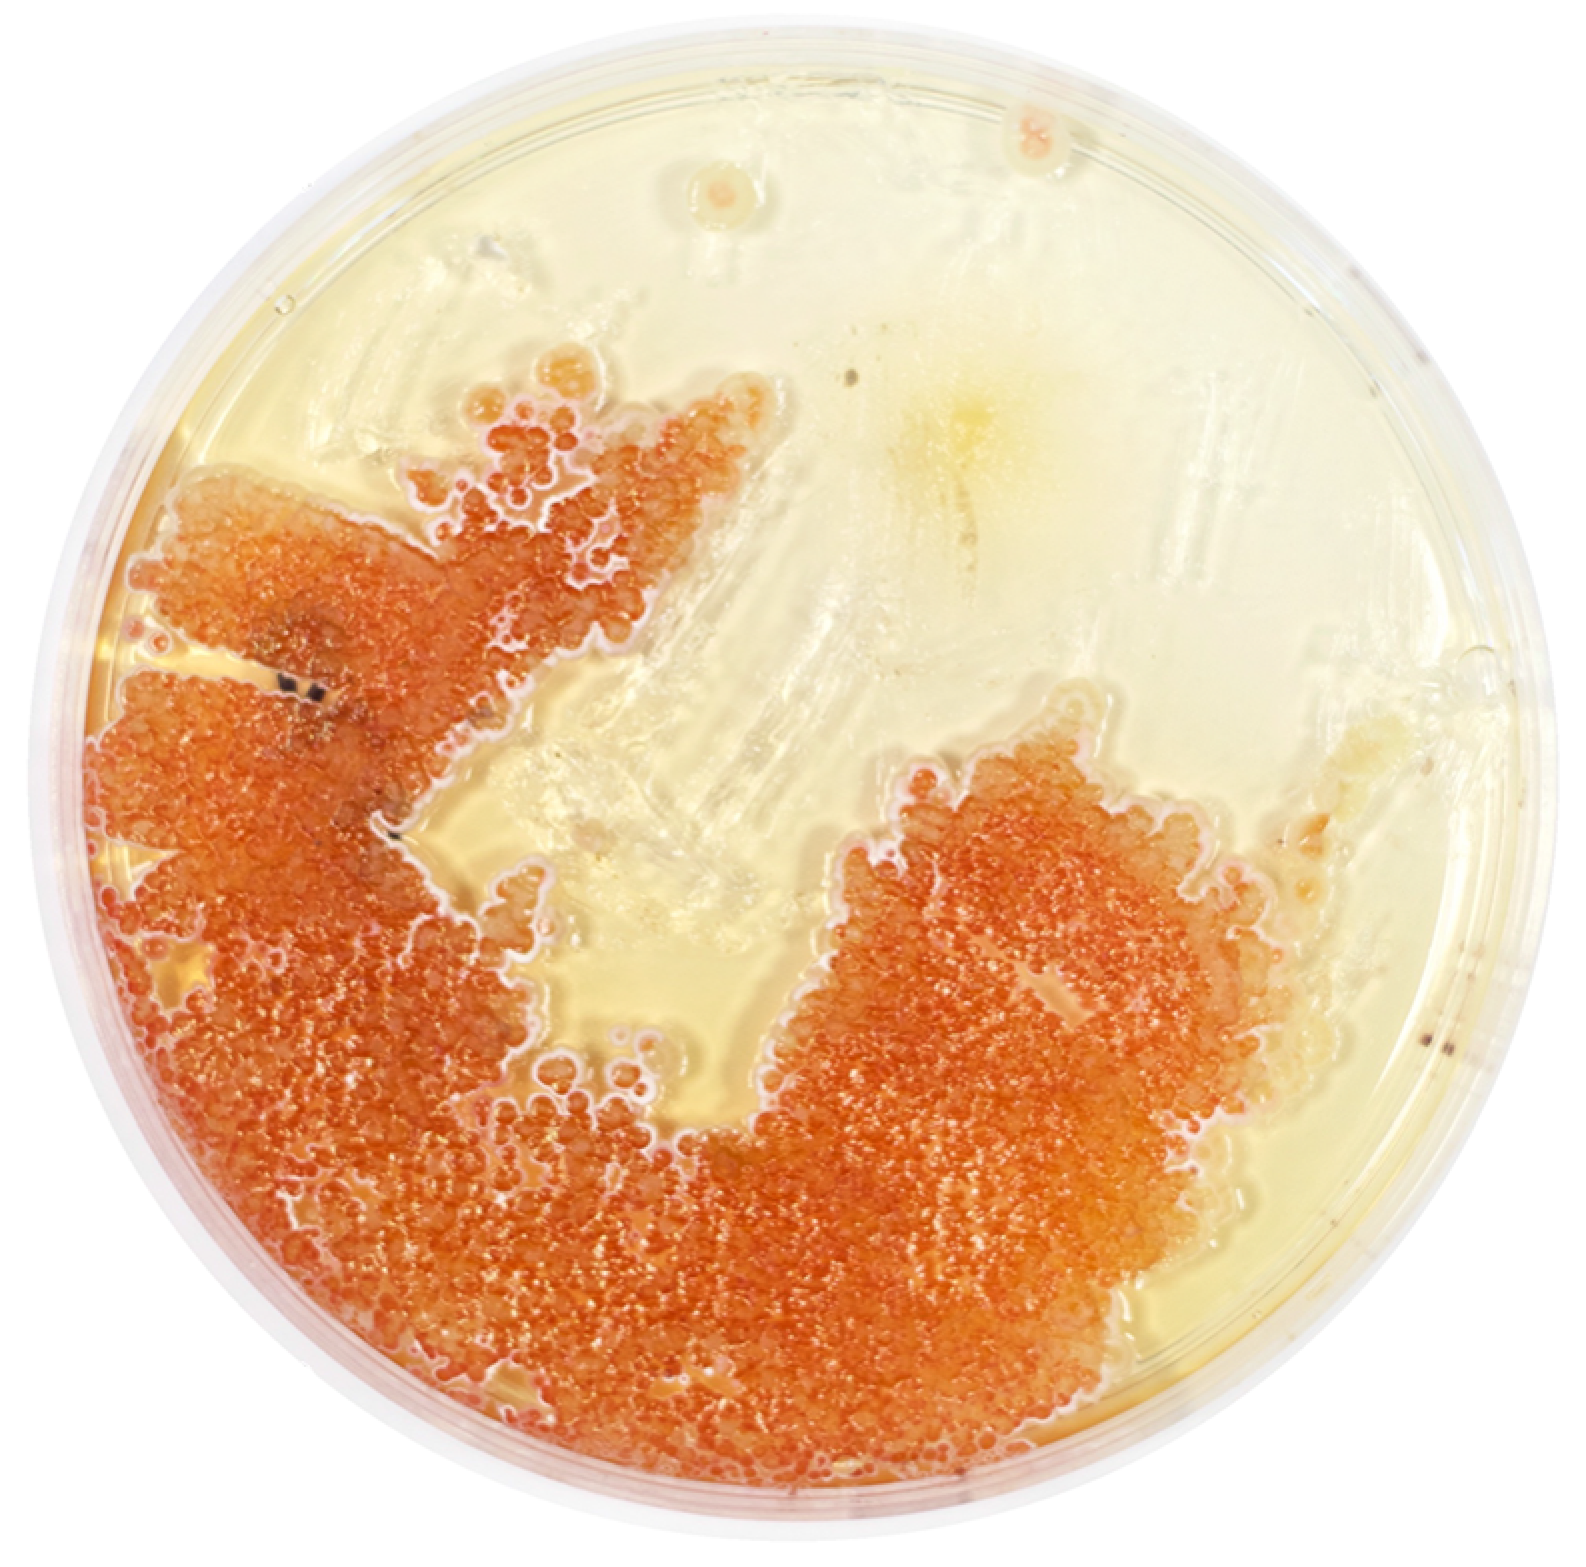
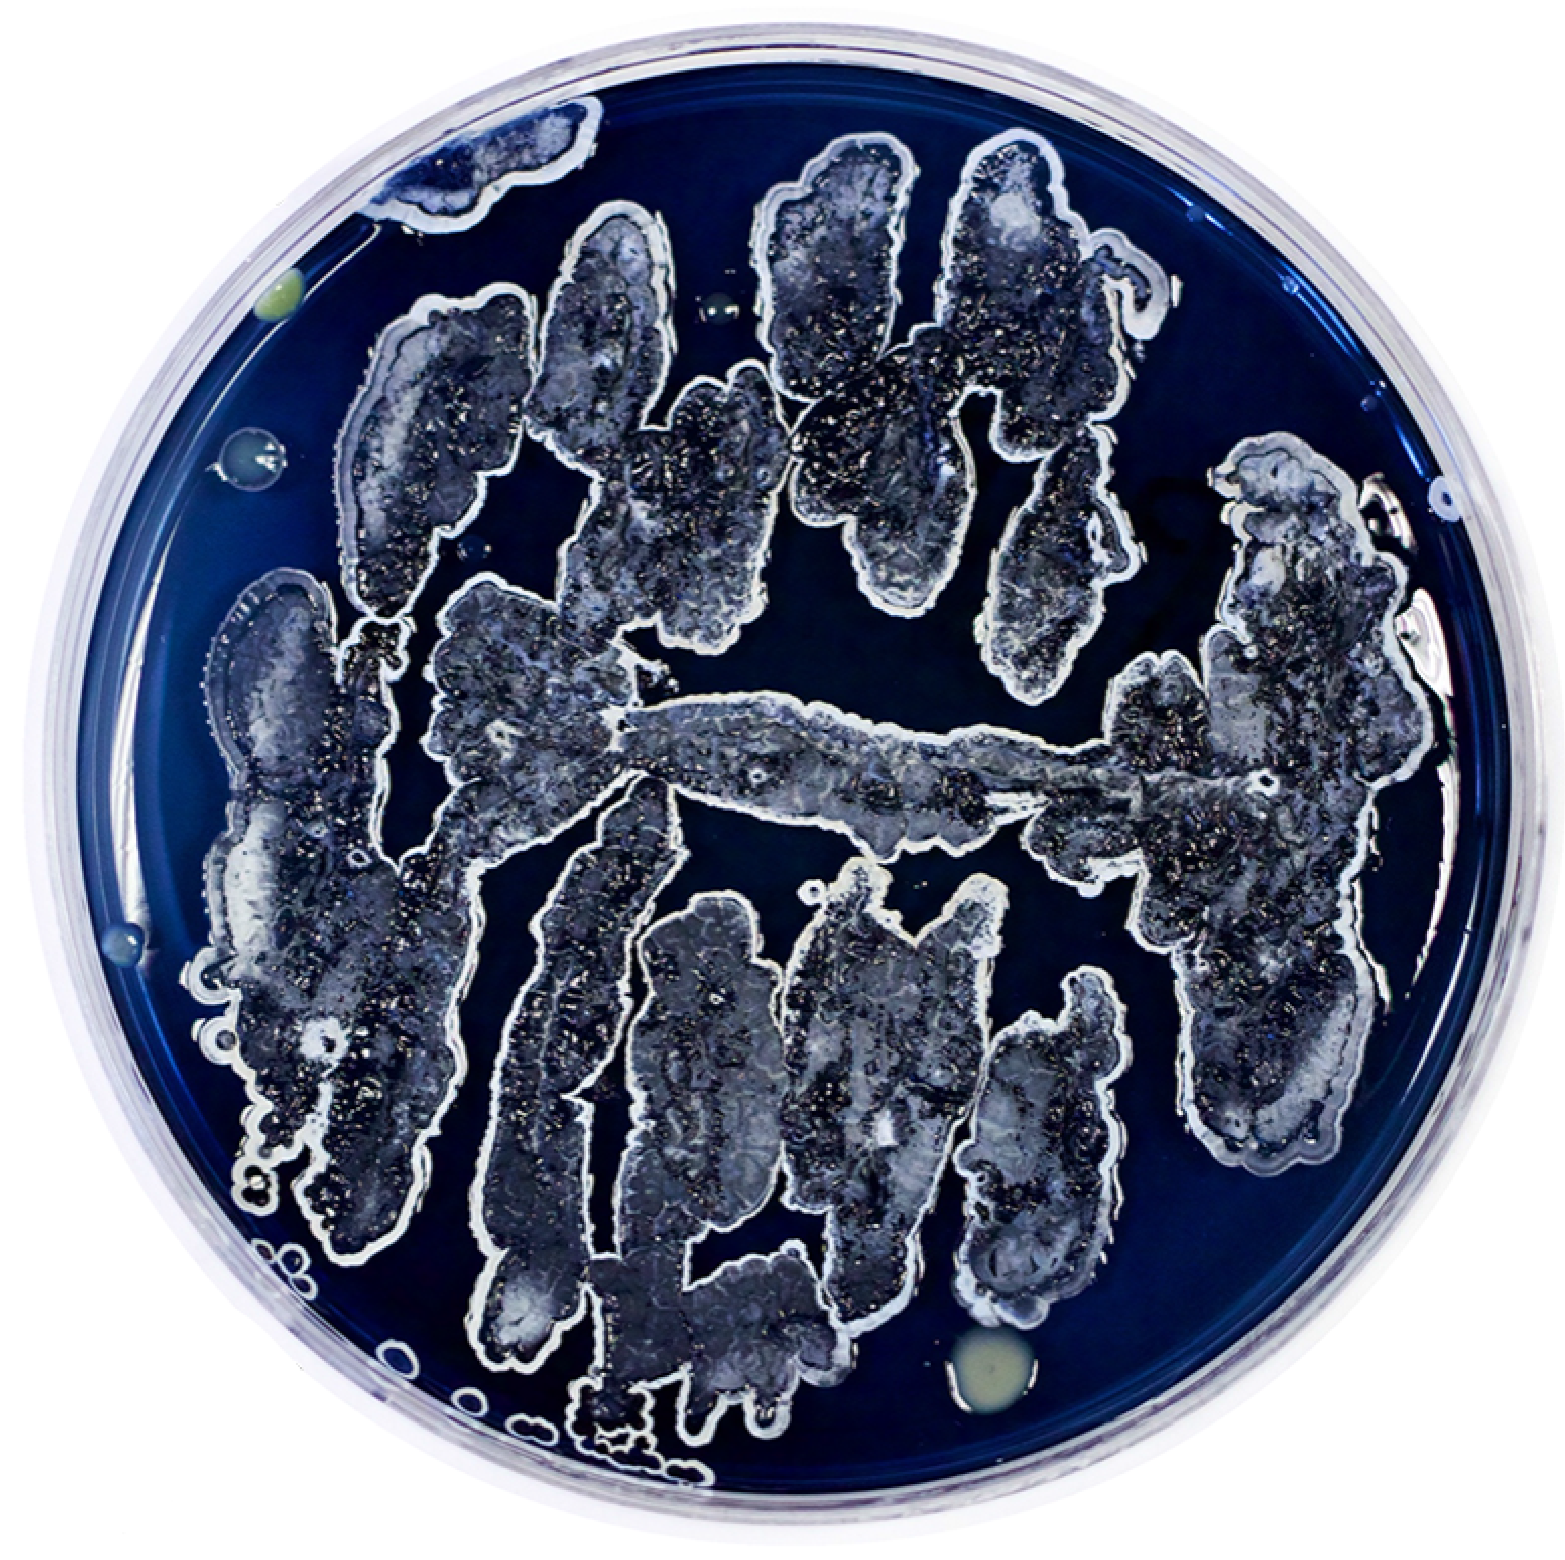

BioArt
We enjoy playing in the fertile ground between art and science by using our bacterial strains to produce living images and bio-based paint!
Streptomyces bacteria produce a wide range of vibrantly-colored molecules. As a result, scientists and artists alike can “paint” a variety of bacterial strains onto petri dishes, implementing the hues of natural products to create unique patterns, pictures, and works of art.
Through a “symbiotic outreach” model, we use BioArt to foster a deep connection between trained and untrained scientists. This melding of art and science reveals the beauty of experimentation, opening minds to the endless possibilities of non-traditional collaboration.
Although laboratory rules may be broken, curiosity reigns!

Related Publications
[1] Lopes LE, Waldis SJ, Terrell SM, Lindgren KA, Charkoudian LK (2018). Vibrant symbiosis: Achieving reciprocal science outreach through biological art. PLoS Biol 16(11): e3000061. https://doi.org/10.1371/journal.pbio.3000061
[2] Charkoudian LK, Fitzgerald JT, Khosla C, Champlin A (2010). In Living Color: Bacterial Pigments as an Untapped Resource in the Classroom and Beyond. PLoS Biol 8(10): e1000510. https://doi.org/10.1371/journal.pbio.1000510
Related Media Coverage
Haverblog: “COOL CLASSES: “Critical Disability Studies: Theory and Practice””
“These Artists with Disabilities and College Students Collab’d to Make BioArt”
“Doing Science With Artists Has Made Me a Better Scientist”
Pamphlet, “Symbiosis: Art, Science, and Community”